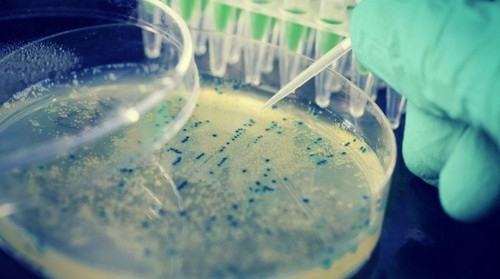

Анализ грудного молока на жирность и стерильность важен для оценки его качества и безопасности для новорожденных. В статье рассмотрим, как проводится анализ на содержание жира и методы посева на стафилококк и другие бактерии для выявления инфекций и нарушений в составе молока. Обсудим значение антител в грудном молоке и где можно пройти эти анализы. Понимание результатов поможет родителям и медицинским работникам обеспечить здоровье младенцев.
Какой состав грудного молока в норме
В первые дни после рождения у женщин вырабатывается молозиво, которое отличается низким содержанием жира, но при этом обладает высокой калорийностью. Это молоко помогает новорожденному адаптироваться к новым условиям жизни, а также способствует заселению его кишечника полезными микроорганизмами. Кроме того, грудное вскармливание в этот период способствует нормализации работы пищеварительной системы. Основное молоко начнет формироваться примерно на четвертый-пятый день после родов. Состав материнского молока изменяется по мере роста ребенка: в первые шесть месяцев в нем содержится больше жиров и белков, а после достижения полугода увеличивается потребность в углеводах и минералах, которые необходимы для полноценного развития костной и суставной систем, а также нервной системы малыша.
Врачи подчеркивают важность анализа грудного молока на жирность и стерильность, так как это может существенно повлиять на здоровье как матери, так и ребенка. Жирность молока играет ключевую роль в обеспечении малыша необходимыми питательными веществами, а ее недостаток может привести к проблемам с ростом и развитием. Стерильность молока также имеет первостепенное значение, поскольку наличие стафилококков и других бактерий может вызвать инфекции у новорожденного. Специалисты рекомендуют регулярно проводить такие анализы, особенно в случае возникновения подозрений на инфекцию или при наличии проблем с лактацией. Это позволит своевременно выявить возможные отклонения и принять необходимые меры для обеспечения здоровья матери и ребенка.
https://youtube.com/watch?v=FBvvs7cz51w
Какие микроорганизмы есть в молоке
Ранее считалось, что материнское молоко абсолютно стерильно, однако недавние исследования показали, что в его состав входят условно патогенные микроорганизмы. При нормальном функционировании иммунной системы они не представляют опасности для малыша. Однако под воздействием определённых факторов, таких как переохлаждение, контакт с инфицированным человеком или прорезывание зубов, эти микроорганизмы могут начать активно размножаться. В случае их избыточного количества могут возникнуть следующие проблемы:
• кожные гнойничковые инфекции;
• дисбиоз кишечника;
• частые простудные заболевания;
• задержка в развитии;
• нарушения работы пищеварительной системы.
Если материнское молоко содержит значительное количество условно-патогенных или патогенных микроорганизмов, это может привести к маститу, что является осложнением лактации. В таком случае из соска может выделяться гной, грудь опухает и вызывает сильную боль. Воспалительный процесс сопровождается повышением температуры до 38-39°C и ознобом. Такое молоко не принесет никакой пользы ребенку. Все перечисленные проблемы могут негативно сказаться на развитии малыша, его прибавка в весе будет ниже ожидаемой нормы, а риск инфицирования значительно возрастет.
Согласно литературным данным, в материнском молоке содержится более 700 видов бактерий, большинство из которых относятся к молочнокислым. Более того, некоторые виды бактерий остаются неизвестными для ученых. Через полгода после рождения состав молока изменяется, что позволяет кишечнику ребенка заселяться другими микроорганизмами.
| Параметр анализа | Цель анализа | Интерпретация результатов |
|---|---|---|
| Жирность грудного молока | Оценка энергетической ценности молока, достаточности питания ребенка. | Норма: 3-5% (может варьироваться). Низкая жирность: Возможно, ребенок не получает достаточно «заднего» молока, проблемы с лактацией. Высокая жирность: Редко является проблемой, но может указывать на особенности питания матери. |
| Стерильность (бактериологический посев) | Выявление патогенных микроорганизмов, таких как стафилококк, стрептококк, кишечная палочка и др. | Отсутствие роста патогенных бактерий: Молоко стерильно, безопасно для ребенка. Выявление условно-патогенных бактерий в низких титрах: Часто является нормой, не требует лечения. Выявление патогенных бактерий (например, золотистый стафилококк) в высоких титрах: Указывает на инфекцию, может быть причиной проблем у ребенка (колики, диарея, сыпь) или мастита у матери. Требует консультации врача и, возможно, лечения. |
| Чувствительность к антибиотикам (при выявлении бактерий) | Определение эффективности различных антибиотиков против обнаруженных бактерий. | Чувствительность к определенному антибиотику: Этот антибиотик будет эффективен для лечения инфекции. Устойчивость к определенному антибиотику: Этот антибиотик не будет эффективен. Помогает врачу выбрать правильное лечение. |
Как правильно собирать молоко для анализа
Для сбора молока на анализ рекомендуется приобрести в аптеке две специальные стерильные емкости.
Перед тем как начать сбор, важно отметить емкости, так как состав молока из правой и левой молочной железы может отличаться.
Подготовка включает в себя определенные гигиенические процедуры: необходимо тщательно вымыть руки и грудь с мылом, а соски и область вокруг них обработать ватным тампоном, смоченным в 70% спирте. Для каждой груди следует использовать отдельный тампон.
Первую порцию молока не стоит включать в анализ, так как это может снизить его точность.
При сцеживании важно избегать контакта краев контейнера с телом.
Для анализа достаточно собрать по 10 мл молока с каждой железы.
После сбора емкости следует плотно закрыть и как можно быстрее доставить в лабораторию.
Замораживать грудное молоко в контейнерах для анализа не рекомендуется, так же как и подвергать его воздействию высоких температур.
Молоко является отличной питательной средой для бактерий, и без естественного контроля они могут быстро размножаться. Поэтому чем быстрее будет проведен анализ, тем выше его точность. Если доставка задерживается более чем на 2 часа, результаты анализа грудного молока могут быть менее информативными.
https://youtube.com/watch?v=Qp4Ftk2PKJE
Что делать если в молоке обнаружили микроорганизмы
Можно ли продолжать грудное вскармливание, если в молоке обнаружены бактерии, зависит от их количества и характеристик. Если у матери отсутствуют воспалительные процессы, но в молоке выявлены микроорганизмы, то кормление грудью допустимо и даже рекомендуется.
При мастите рекомендуется прикладывать ребенка к здоровой груди.
Если анализ показал наличие стафилококка и имеются клинические признаки инфекции, необходимо провести антибактериальную терапию с учетом чувствительности к возбудителю.
Не всегда наличие стафилококка в молоке матери является основанием для лечения, так как добиться полной стерильности при анализе невозможно. Микробы могут попасть в образец с кожи или из окружающей среды. Если мама и малыш чувствуют себя хорошо, то лечение не требуется, и прекращать лактацию не следует.
Существуют антибиотики, которые безопасны для приема во время лактации и не представляют угрозы для ребенка. Пока состояние малыша не нормализуется, его прикладывают к здоровой груди, а больную регулярно сцеживают. К разрешенным антибиотикам во время грудного вскармливания относятся препараты из следующих групп:
• защищенные пенициллины;
• цефалоспорины;
• макролиды.
Для восстановления полезной микрофлоры в организме применяются эубиотики, которые заселяют кишечник полезными бактериями и создают оптимальные условия для роста «хороших» микроорганизмов. Такие биологически активные добавки можно давать детям с первых дней жизни, если у кормящей мамы или у самого ребенка возникает необходимость в антибиотиках.
Стафилококковая инфекция у ребенка может вызвать ряд серьезных состояний:
• Конъюнктивит (воспаление конъюнктивы глаз: покраснение век, гнойные выделения, отек, резь).
• Омфалит (воспаление пупка).
• Энтероколит (воспалительный процесс в желудочно-кишечном тракте: боли в животе, диарея, стул с кровью и слизью, рвота и тошнота).
• Стафилодермия (появление на коже специфических пузырьков с гноем, зуд, покраснение).
• Сепсис.
• Флегмоны и абсцессы.
Для возникновения вышеописанных заболеваний у ребенка недостаточно лишь действия микроба; необходим также сбой иммунной системы и дополнительный источник инфекции.
Важно! Анализ на стафилококк следует проводить, если у ребенка наблюдается пиодермия (гнойничковое поражение кожи).
Как и при любых гнойно-воспалительных процессах, общее состояние ребенка может ухудшаться, что проявляется повышением температуры, отказом от пищи, беспокойством, плачем, вялостью и нарушением сна. После проведения антибактериальной терапии состояние обычно нормализуется.
Расшифровка анализа грудного молока на стерильность
Следует помнить, что результаты посева молока на микрофлору будут готовы примерно через неделю, так как культуральный метод требует определенного времени. Возможные выводы следующие:
-
Патогенные микроорганизмы не обнаружены – данный вариант встречается довольно редко, так как молоко не должно быть абсолютно стерильным.
-
Обнаружены условные патогены в допустимых количествах. Это состояние не представляет опасности для ребенка, принимать лекарства не требуется, рекомендуется продолжать грудное вскармливание.
-
Зафиксирован рост патогенной микрофлоры в количестве, не превышающем 250 КОЕ/мл. Такой результат указывает на наличие патогенных микроорганизмов, но их количество недостаточно для возникновения какого-либо заболевания. Терапия не требуется, можно спокойно продолжать грудное вскармливание.
-
Обнаружена патогенная микрофлора в количестве колоний, превышающем допустимый уровень — свыше 250 КОЕ/мл. Это молоко представляет опасность для здоровья малыша, рекомендуется провести антибактериальную терапию для матери, а в случае появления признаков недомогания у ребенка, необходимо совместное лечение.
https://youtube.com/watch?v=dq0JxLhmCkQ
Определение жирности материнского молока
Жирность молока играет важную роль в обеспечении насыщения и полноценного развития ребенка. Недостаток жиров в молоке может привести к тому, что малыш не получает достаточного количества питательных веществ и отстает в своем развитии от сверстников. С другой стороны, избыточная жирность может вызвать дисбактериоз кишечника, так как в организме может не хватать ферментов для переработки большого количества жиров. Непереваренные вещества могут привести к гнилостным процессам в кишечнике, что проявляется в виде вздутия живота, кишечных колик и частого жидкого стула с остатками непереваренной пищи. Следует отметить, что в первой порции молока содержится меньше жиров, поэтому для анализа рекомендуется сдавать «заднее» молоко, полученное после 5 минут кормления.
Существует специальный прибор для определения жирности молока, который называется бутирометр. Анализ грудного молока на содержание жиров следует проводить, если у ребенка наблюдаются проблемы с желудочно-кишечным трактом.
Нормальный показатель жирности составляет 3,5 — 3,8%.
Прочие исследования
Определение удельного веса
Анализ проводится для определения соотношения белков и жиров. Удельный вес молока не остается неизменным, поэтому результаты могут варьироваться. Не рекомендуется собирать молоко для анализа сразу после кормления; для получения точных данных необходимо сделать перерыв в лактации минимум на полтора-два часа.
Для анализа используется ареометр при температуре 15°C. Нормальные показатели находятся в диапазоне от 1,026 до 1,036.
Определение уровня антител в грудном молоке
Наибольшее количество иммуноглобулинов А обнаруживается в молозиве. Спустя 7-10 дней их выработка снижается и остается на стабильном уровне на протяжении всего младенческого периода. Кроме иммуноглобулинов А, в составе молока также можно найти интерлейкины, макрофаги, лимфоциты, а также иммуноглобулины М и G.
Где можно сдать анализ грудного молока
В муниципальных поликлиниках такие анализы не выполняются, однако частные лаборатории предлагают эту услугу. Направление от врача не требуется.
Влияние хранения и транспортировки молока на результаты анализа
Хранение и транспортировка грудного молока играют критическую роль в обеспечении его качества и безопасности. Неправильные условия хранения могут привести к изменению физико-химических свойств молока, что, в свою очередь, может повлиять на результаты анализа на жирность и стерильность.
Одним из основных факторов, влияющих на качество грудного молока, является температура хранения. Оптимальная температура для хранения молока составляет от 0 до 4 градусов Цельсия. При более высоких температурах происходит активное размножение микроорганизмов, что может привести к повышению уровня бактерий, включая стафилококки. Эти бактерии могут вызывать различные инфекции и негативно сказываться на здоровье как матери, так и ребенка.
Кроме того, длительное хранение молока даже при низких температурах может привести к окислению жиров, что негативно сказывается на его жирности и питательной ценности. Окисленные жиры могут изменять вкус и запах молока, а также снижать его полезные свойства. Поэтому важно не только поддерживать низкую температуру, но и минимизировать время хранения молока перед его анализом.
Транспортировка грудного молока также требует особого внимания. Молоко должно быть помещено в стерильные контейнеры, которые обеспечивают герметичность и защиту от внешних загрязнений. В процессе транспортировки необходимо поддерживать постоянную низкую температуру, чтобы предотвратить размножение бактерий. Использование термосумок или специальных холодильных установок может существенно повысить безопасность и качество молока.
Важно отметить, что даже кратковременные нарушения температурного режима могут привести к значительным изменениям в составе молока. Например, при температуре выше 4 градусов Цельсия уже через несколько часов может наблюдаться рост патогенных микроорганизмов, что сделает молоко непригодным для употребления и анализа.
Таким образом, для получения точных и надежных результатов анализа грудного молока на жирность и стерильность необходимо строго соблюдать условия хранения и транспортировки. Это включает в себя контроль температуры, использование стерильной упаковки и минимизацию времени между сбором молока и его анализом. Только при соблюдении этих условий можно гарантировать, что результаты анализа будут отражать истинное состояние молока и его безопасность для ребенка.
Рекомендации по улучшению качества грудного молока
Для обеспечения высокого качества грудного молока, которое является основным источником питания для новорожденных, необходимо учитывать несколько факторов, влияющих на его состав и безопасность. Важнейшими аспектами, которые следует учитывать, являются правильное питание матери, соблюдение гигиенических норм и регулярные медицинские обследования.
1. Правильное питание матери: Качество грудного молока напрямую зависит от рациона питания кормящей матери. Важно, чтобы в рационе присутствовали все необходимые макро- и микроэлементы. Белки, жиры, углеводы, витамины и минералы должны быть сбалансированы. Рекомендуется включать в рацион больше свежих фруктов и овощей, молочных продуктов, нежирного мяса и рыбы. Избегайте употребления алкоголя, кофеина и продуктов с высоким содержанием сахара и консервантов.
2. Соблюдение гигиенических норм: Гигиена играет ключевую роль в поддержании стерильности грудного молока. Кормящая мать должна тщательно мыть руки перед каждым кормлением, а также следить за чистотой груди. Рекомендуется использовать специальные прокладки для груди, которые помогут предотвратить попадание бактерий и загрязнений. Также стоит избегать контакта молока с посторонними предметами и поверхностями.
3. Регулярные медицинские обследования: Кормящим матерям следует регулярно проходить медицинские обследования, чтобы исключить наличие инфекций, таких как стафилококк, которые могут негативно сказаться на качестве молока. В случае выявления каких-либо заболеваний необходимо следовать рекомендациям врача и, при необходимости, временно прекратить грудное вскармливание.
4. Условия хранения молока: Если грудное молоко необходимо хранить, важно соблюдать правильные условия. Молоко следует хранить в стерильных контейнерах, которые можно помещать в холодильник или морозильник. При этом важно помнить, что замороженное молоко можно хранить не более 6 месяцев, а размороженное — не более 24 часов в холодильнике. Нельзя повторно замораживать молоко после его размораживания.
5. Образ жизни и стресс: Психоэмоциональное состояние матери также влияет на качество грудного молока. Стресс и недостаток сна могут негативно сказаться на его составе. Рекомендуется уделять внимание отдыху, заниматься физической активностью и находить время для расслабления. Поддержка со стороны семьи и друзей также играет важную роль в создании комфортной обстановки для кормящей матери.
Следуя этим рекомендациям, можно значительно улучшить качество грудного молока, что, в свою очередь, положительно скажется на здоровье и развитии ребенка. Забота о собственном здоровье и соблюдение гигиенических норм — это залог не только качественного молока, но и благополучия всей семьи.
Сравнение грудного молока с искусственными смесями по составу и стерильности
Грудное молоко является уникальным продуктом, который обеспечивает новорожденным все необходимые питательные вещества и антитела для формирования иммунной системы. В отличие от искусственных смесей, которые разрабатываются на основе коровьего молока или соевых белков, грудное молоко содержит оптимальное соотношение белков, жиров, углеводов, витаминов и минералов, что делает его незаменимым для младенцев.
Состав грудного молока варьируется в зависимости от различных факторов, таких как возраст ребенка, время суток и даже диета матери. В среднем, грудное молоко состоит из 87% воды, 7% углеводов (в основном лактозы), 4% жиров и 1% белков. Жиры в грудном молоке представлены в виде триглицеридов, которые обеспечивают высокую энергетическую ценность и способствуют усвоению жирорастворимых витаминов. Искусственные смеси, хотя и могут быть обогащены витаминами и минералами, часто не могут полностью воспроизвести сложный состав грудного молока.
Что касается стерильности, грудное молоко обладает естественными антимикробными свойствами благодаря наличию иммуноглобулинов, лизоцима и других биологически активных веществ. Эти компоненты помогают защищать новорожденного от инфекций, особенно в первые месяцы жизни. В то время как искусственные смеси могут подвергаться пастеризации и другим методам обработки для уничтожения патогенных микроорганизмов, они не содержат тех же защитных факторов, что и грудное молоко.
При анализе грудного молока на наличие стафилококков и других бактерий, важно отметить, что здоровое грудное молоко обычно стерильно или содержит минимальное количество микробов. Однако, в случае неправильного хранения или недостаточной гигиены, грудное молоко может стать источником инфекции. Искусственные смеси, в свою очередь, могут быть более подвержены бактериальному загрязнению, особенно если они не были правильно приготовлены или хранились в ненадлежащих условиях.
Таким образом, грудное молоко не только превосходит искусственные смеси по питательным свойствам, но и обеспечивает более высокий уровень стерильности благодаря своим естественным защитным механизмам. Это делает его предпочтительным выбором для кормления новорожденных, особенно в первые месяцы жизни, когда иммунная система ребенка еще формируется.